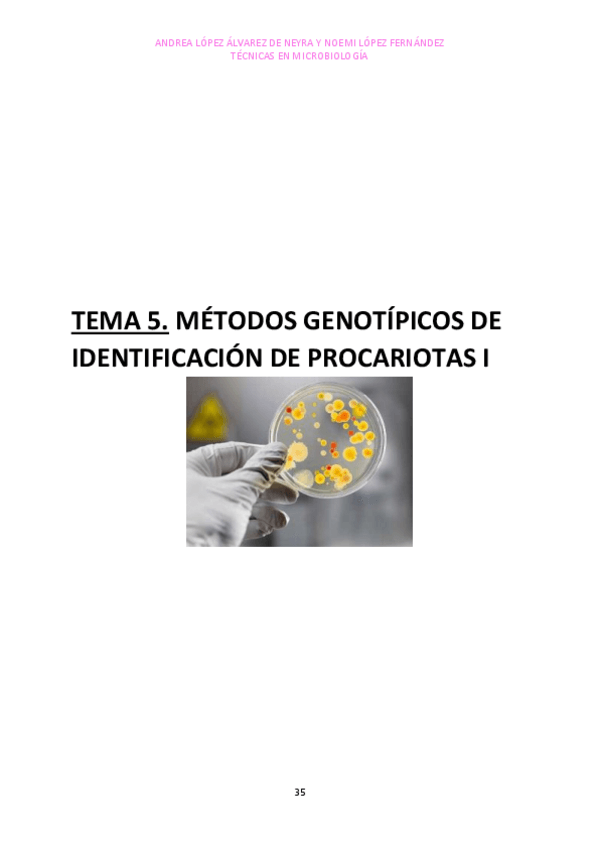

Técnicas en Microbiología
He publicado nuevos apuntes de 3º Técnicas en Microbiología: Practicas-TM.pdf
Un miniresumen de las prácticas que me hice para que me fuera más fácil estudiar
He publicado nuevos apuntes de 3º Técnicas en Microbiología: Apuntes-T1-a-T5.pdf
He publicado nuevos apuntes de 3º Técnicas en Microbiología: PRACTICAS-TM.pdf
He publicado nuevos apuntes de 3º Técnicas en Microbiología: Practicas-TM.pdf
He publicado nuevos apuntes de 3º Técnicas en Microbiología: Apuntes-Tecnicas-en-Microbiologia.pdf
apuntes
-
APUNTES COMPLETOS
He publicado nuevos apuntes de 3º Técnicas en Microbiología: APUNTES COMPLETOS
apuntes
-
Técnicas en Microbiología
He publicado nuevos apuntes de 3º Técnicas en Microbiología: Técnicas en Microbiología

¡Estás al día!
Has visto todos los archivos